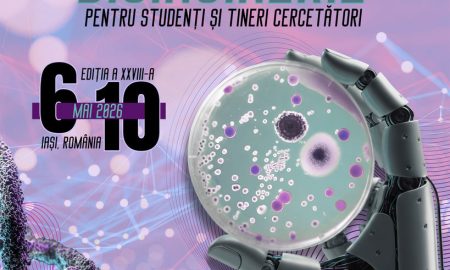

All posts tagged "evenimente umf iasi"
-

 15Evenimente
15EvenimenteConferința Națională de Bioinginerie pentru Studenți și Tineri Cercetători
Asociația Studenților Bioingineri încununează activitatea desfășurată pe parcursul anului universitar curent cu un eveniment de amploare, menit să valorifice creativitatea tuturor studenților...
-

 118Evenimente
118EvenimenteAdelin Petrisor – Conferinta “Jurnalismul in era social media” & lansare de carte @ UMF, 26 Februarie
Joi, 26 februarie 2026, Universitatea de Medicină și Farmacie „Grigore T. Popa” din Iași găzduiește, în Aula „George Emil Palade”, un eveniment...